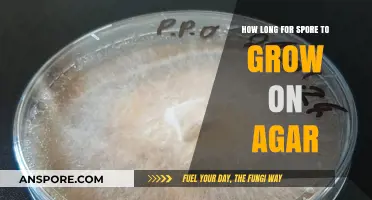
Optimal Conditions for Spore Growth on Agar: Timeframe Explained

Milky spore, a natural bacterium scientifically known as *Paenibacillus popilliae*, is widely used as an environmentally friendly method to control Japanese beetle grubs in lawns and gardens. Once applied to the soil, milky spore can remain viable for many years, often persisting for a decade or more under favorable conditions. Its longevity depends on factors such as soil type, moisture levels, temperature, and the presence of host grubs, as the bacterium thrives by infecting and multiplying within the larvae. While it may gradually decline in effectiveness over time, periodic reapplication is generally unnecessary unless grub populations resurge or environmental conditions significantly change. This makes milky spore a cost-effective and sustainable solution for long-term pest management.
| Characteristics | Values |
|---|---|
| Survival Time in Soil | 15–20 years or more under optimal conditions |
| Effectiveness Period | Active for up to 10–15 years after application |
| Optimal Soil Conditions | Neutral pH (6.5–7.5), well-drained soil, and consistent moisture |
| Temperature Requirements | Most active in soil temperatures between 60°F and 90°F (15°C–32°C) |
| Persistence in Adverse Conditions | Reduced longevity in extreme cold, drought, or highly acidic/alkaline soils |
| Reapplication Interval | Typically every 10–15 years for continued grub control |
| Microbial Activity | Remains dormant in soil until Japanese beetle grubs are present |
| Environmental Impact | Non-toxic, safe for humans, pets, and beneficial soil organisms |
| Compatibility with Other Treatments | Can be used alongside other organic pest control methods |
| Soil Type Preference | Most effective in loamy or sandy soils with good aeration |
Explore related products
What You'll Learn
- Milky Spore Persistence: How long does milky spore remain active and viable in soil after application
- Soil Conditions Impact: Do soil type, pH, or moisture levels affect milky spore longevity
- Temperature Effects: How do varying soil temperatures influence milky spore survival over time
- Reapplication Timing: When should milky spore be reapplied to maintain its effectiveness in the soil
- Microbial Interactions: Do other soil microorganisms affect milky spore’s lifespan or activity

Milky Spore Persistence: How long does milky spore remain active and viable in soil after application?
Milky spore, a biological control agent derived from the bacterium *Paenibacillus popilliae*, is renowned for its effectiveness against Japanese beetle grubs. Once applied to the soil, its longevity becomes a critical factor for gardeners and landscapers seeking long-term grub control. Research indicates that milky spore can remain viable in the soil for 10 to 20 years, provided optimal conditions are met. This extended persistence makes it a cost-effective solution compared to chemical pesticides, which often require annual reapplication. However, this timeframe is not absolute; factors such as soil pH, moisture levels, and temperature fluctuations can influence its survival.
To maximize milky spore’s longevity, application timing and technique are crucial. Apply the spores in late summer or early fall when grubs are actively feeding near the soil surface. Use a dosage of 1 to 2 teaspoons per 10 square feet, evenly distributed across the treated area. Water the soil lightly after application to activate the spores and ensure they penetrate the root zone. Avoid overwatering, as excessive moisture can dilute the spore concentration and reduce effectiveness. For larger areas, consider using a spreader to achieve uniform coverage.
While milky spore’s persistence is impressive, it’s not a one-time solution for all grub infestations. Its efficacy depends on the presence of susceptible grubs in the soil. If grub populations are low or absent, the spores may remain dormant until a new generation emerges. This dormancy is a strength, as it allows the spores to "wait" for their target, but it also means that immediate results may not be visible. Patience is key; it can take 2 to 3 years for milky spore to establish itself fully and significantly reduce grub populations.
Comparing milky spore to chemical alternatives highlights its unique advantages. Chemical pesticides degrade within months and often harm beneficial soil organisms, whereas milky spore persists for years and is safe for pets, humans, and the environment. However, it’s not a quick fix. For severe infestations, combining milky spore with other methods, such as nematodes or manual grub removal, can accelerate control. Regular monitoring of grub activity will help determine if additional applications are needed.
In practice, maintaining soil health is essential for milky spore’s long-term viability. Keep the soil pH between 6.0 and 7.5, as extreme acidity or alkalinity can inhibit spore activity. Incorporate organic matter, such as compost, to improve soil structure and microbial activity, which supports spore proliferation. Avoid using broad-spectrum insecticides, as they can inadvertently kill the milky spore bacteria. By creating a favorable soil environment, you ensure that milky spore remains active and effective for its full potential lifespan.
Can Steam Mops Effectively Eliminate Mold Spores in Your Home?
You may want to see also

Soil Conditions Impact: Do soil type, pH, or moisture levels affect milky spore longevity?
Milky spore, a bacterium used to control Japanese beetle grubs, thrives under specific soil conditions. Its longevity in the soil is not a fixed duration but a variable influenced by factors such as soil type, pH, and moisture levels. Understanding these interactions is crucial for maximizing its effectiveness as a biological control agent. For instance, milky spore (Paenibacillus popilliae) can persist in the soil for up to 20 years under optimal conditions, but this duration is significantly shortened when environmental factors deviate from its preferences.
Soil type plays a pivotal role in milky spore’s survival. Sandy soils, with their larger particles and lower water-holding capacity, often reduce the bacterium’s longevity due to increased drainage and reduced nutrient retention. In contrast, loamy soils, which balance drainage and moisture retention, provide an ideal environment for milky spore to thrive. Clay soils, while nutrient-rich, can become waterlogged, limiting oxygen availability and potentially suffocating the bacterium. To optimize milky spore’s lifespan, amend sandy soils with organic matter to improve moisture retention and aerate clay soils to enhance oxygen flow.
PH levels are another critical factor affecting milky spore’s viability. This bacterium performs best in slightly acidic to neutral soils, with a pH range of 6.0 to 7.5. Soils with pH levels outside this range can inhibit spore germination and bacterial activity. For example, highly acidic soils (pH below 6.0) may reduce milky spore’s effectiveness, while alkaline soils (pH above 7.5) can similarly hinder its growth. Testing soil pH and adjusting it with lime or sulfur, as needed, ensures a favorable environment for milky spore.
Moisture levels are equally important, as milky spore requires consistent soil moisture to remain active. Prolonged drought conditions can desiccate the spores, rendering them ineffective, while excessive moisture can lead to waterlogging and oxygen deprivation. Maintaining soil moisture at 50-70% of field capacity is ideal. During dry periods, supplemental irrigation may be necessary, while proper drainage systems can prevent waterlogging in wet conditions.
In practice, combining these factors requires a tailored approach. For example, in a sandy soil with a pH of 5.8 and low moisture, one might apply 5-10 pounds of milky spore per 1,000 square feet, incorporate organic matter to improve moisture retention, and add agricultural lime to raise the pH to 6.5. Regular monitoring of soil conditions ensures the bacterium’s longevity and effectiveness. By addressing soil type, pH, and moisture levels, gardeners and landscapers can create an environment where milky spore thrives, providing long-term control of Japanese beetle grubs.
Effective Techniques for Removing Fungal Spores in Mold Remediation
You may want to see also

Temperature Effects: How do varying soil temperatures influence milky spore survival over time?
Soil temperature plays a pivotal role in determining the longevity and efficacy of milky spore, a biological control agent used to combat Japanese beetle grubs. Research indicates that milky spore (*Paenibacillus popilliae*) thrives in soil temperatures ranging between 60°F and 85°F (15°C to 29°C). Within this optimal range, the spores remain viable for up to 20 years, effectively infecting and reducing grub populations. However, temperatures outside this window can significantly shorten their survival time. For instance, prolonged exposure to temperatures below 50°F (10°C) or above 90°F (32°C) can degrade spore viability, reducing their lifespan to as little as 2–5 years.
To maximize milky spore’s effectiveness, timing application with seasonal temperature trends is crucial. Early fall, when soil temperatures are consistently between 60°F and 70°F (15°C to 21°C), is ideal. This allows spores to establish before winter dormancy and ensures they are active when grubs are most vulnerable. Conversely, applying milky spore during peak summer heat or in freezing winter conditions can render the treatment ineffective, as extreme temperatures hinder spore germination and replication.
A comparative analysis of milky spore survival in different climates reveals stark differences. In temperate regions with moderate seasonal fluctuations, spores often persist for the full 20-year lifespan. In contrast, arid or tropical climates with consistently high temperatures may see spore viability drop to 5–10 years. Similarly, colder climates with prolonged winters may experience reduced efficacy due to insufficient warm periods for spore activity. For gardeners in such regions, supplementing milky spore with other grub control methods may be necessary.
Practical tips for optimizing milky spore survival include monitoring soil temperature with a thermometer before application and avoiding treatment during heatwaves or frosts. Additionally, incorporating organic matter into the soil can help moderate temperature extremes, creating a more stable environment for spores. For those in challenging climates, reapplying milky spore every 5–10 years may be required to maintain consistent grub control.
In conclusion, temperature is a critical factor in milky spore’s longevity and effectiveness. By understanding and leveraging optimal soil temperature ranges, gardeners can ensure this biological control remains a reliable tool for decades. Ignoring temperature considerations, however, risks wasting time and resources on a treatment that may fail to deliver lasting results.
Activated Charcoal: Effective Mold Spores and Odor Remover?
You may want to see also
Explore related products

Reapplication Timing: When should milky spore be reapplied to maintain its effectiveness in the soil?
Milky spore, a natural bacterium (Paenibacillus popilliae), targets Japanese beetle grubs in the soil, offering long-term control. Once established, it can persist for decades under ideal conditions. However, its effectiveness hinges on proper reapplication timing. While milky spore doesn’t "expire," its population can dwindle over time due to environmental factors like soil pH, moisture, and organic matter. Reapplication becomes necessary when grub populations resurge or when soil conditions no longer support the bacterium’s survival.
To determine reapplication timing, monitor your lawn for signs of Japanese beetle activity. If you notice increased grub damage, such as brown patches or spongy turf, it’s a clear indicator that milky spore levels may have declined. Typically, reapplication is recommended every 5 to 10 years, depending on soil health and grub pressure. For high-risk areas or heavily infested lawns, a more frequent schedule—every 3 to 5 years—may be necessary. Always follow product instructions, as some formulations require specific application rates (e.g., 1 to 2 teaspoons per square foot) for optimal results.
Environmental factors play a critical role in milky spore’s longevity. In acidic soils (pH below 6.0), the bacterium struggles to thrive, necessitating more frequent reapplication. Conversely, neutral to slightly alkaline soils (pH 6.5–7.5) promote its survival. Additionally, consistent moisture is essential; dry soils can reduce milky spore’s effectiveness, while waterlogged conditions may wash it away. To maximize its lifespan, apply milky spore during late summer or early fall when grubs are actively feeding and soil temperatures are warm (60–70°F), fostering rapid bacterial growth.
Comparing milky spore to chemical treatments highlights its reapplication advantages. Unlike synthetic pesticides, which degrade quickly and require annual applications, milky spore builds a self-sustaining population over time. However, this doesn’t mean it’s maintenance-free. Periodic reapplication ensures its presence remains robust enough to combat new generations of grubs. Think of it as a long-term investment: while initial applications may take 2–3 years to show significant results, proper reapplication timing maintains its efficacy for decades, reducing the need for costly and environmentally harmful alternatives.
For practical implementation, start by dividing your lawn into sections and applying milky spore in a grid pattern to ensure even coverage. Water the area thoroughly after application to activate the spores. Keep records of application dates and monitor grub activity annually to track effectiveness. If reapplication is needed, focus on problem areas first before treating the entire lawn. By staying proactive and responsive to soil and pest conditions, you can maintain milky spore’s effectiveness and enjoy a grub-free lawn year after year.
Microwaving Glass MMJ: Effective Method to Eliminate Spores?
You may want to see also

Microbial Interactions: Do other soil microorganisms affect milky spore’s lifespan or activity?
Soil is a bustling ecosystem teeming with microorganisms, each playing a role in nutrient cycling, disease suppression, and plant health. Among these, *Paenibacillus popilliae*, commonly known as milky spore, is a biological control agent used to combat Japanese beetle larvae. While milky spore’s persistence in soil is often cited as 10–20 years, this lifespan isn’t static. Other soil microorganisms can significantly influence its activity and longevity, either by competing for resources, producing antagonistic compounds, or forming symbiotic relationships. Understanding these microbial interactions is crucial for maximizing milky spore’s effectiveness in pest management.
Consider the competitive dynamics at play. Soil bacteria and fungi often vie for the same organic matter and nutrients that milky spore relies on to survive. For instance, high populations of *Trichoderma* fungi, known for their antagonistic behavior, can outcompete milky spore for resources, reducing its viability over time. Similarly, certain nitrogen-fixing bacteria may alter soil chemistry in ways that favor their own growth while inhibiting milky spore’s spore germination. To mitigate this, ensure milky spore is applied at the recommended rate of 1–2 billion spores per acre, and avoid excessive tilling, which can disrupt its establishment in the soil.
Conversely, some microorganisms may enhance milky spore’s activity. Mycorrhizal fungi, for example, form symbiotic relationships with plant roots, improving nutrient uptake and potentially creating a more favorable environment for milky spore. Additionally, beneficial bacteria like *Bacillus subtilis* can suppress pathogens that might otherwise harm milky spore. When applying milky spore, consider pairing it with compatible microbial inoculants to create a supportive soil microbiome. However, avoid mixing it with chemical pesticides, as these can indiscriminately kill beneficial microorganisms, including milky spore.
Practical tips for optimizing milky spore’s lifespan include monitoring soil pH, which should ideally be between 6.0 and 7.5 for optimal spore activity. Regularly test soil health to assess microbial diversity, as a balanced ecosystem is less likely to favor competitors over milky spore. For gardeners, applying milky spore in early summer, when Japanese beetle larvae are actively feeding, increases its chances of establishment. Farmers should rotate crops to prevent soil depletion and maintain a diverse microbial community.
In conclusion, milky spore’s lifespan in soil is not an isolated phenomenon but a product of complex microbial interactions. By understanding these dynamics and taking proactive steps to foster a supportive soil environment, you can ensure milky spore remains an effective tool in your pest management arsenal for years to come.
Bacterial Spores: Their Role in Reproduction and Survival Explained
You may want to see also
Frequently asked questions
Milky spore can remain viable in the soil for up to 20 years or more, depending on environmental conditions such as soil type, moisture, and temperature.
Once established, milky spore typically does not require reapplication unless soil conditions change significantly or the population of Japanese beetle grubs increases dramatically.
While milky spore can persist for many years, its effectiveness may diminish if the Japanese beetle grub population declines to very low levels, as the spores rely on the grubs as hosts to multiply.